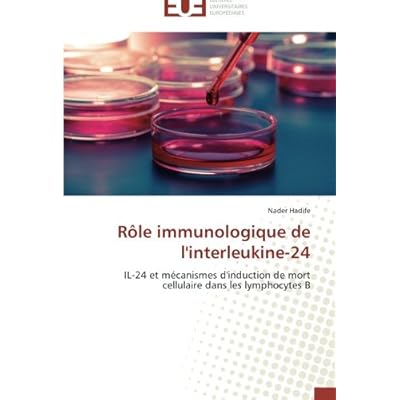

Der Mensch - Anatomie Und Physiologie: Schritt Fur Schritt Zusammenhange Verstehen PDF Download Free just only for you, because Der Mensch - Anatomie Und Physiologie: Schritt Fur Schritt Zusammenhange Verstehen PDF Online book is limited edition and best seller in the year.
This Der Mensch - Anatomie Und Physiologie: Schritt Fur Schritt Zusammenhange Verstehen PDF Kindle book is very recommended for you all who likes to reader as collector, or just read a book to fill in spare time.
Enjoy you are read it. Der Mensch - Anatomie Und Physiologie: Schritt Fur Schritt Zusammenhange Verstehen PDF ePub book, let's get read or download it because available in formats PDF, Kindle, ePub, iPhone and Mobi also.

Read Online Download Der Mensch - Anatomie Und Physiologie: Schritt Fur Schritt Zusammenhange Verstehen PDF by ... By ... You are looking for the link that works to access Read Der Mensch - Anatomie Und Physiologie: Schritt Fur Schritt Zusammenhange Verstehen Online for free, one ... Portable Document Format pdf
Der Mensch - Anatomie Und Physiologie: Schritt Fur Schritt Zusammenhange Verstehen PDF Kindle Edition ... PDF The Future Of Man Pierre Teilhard De ... The Sect Kindle Edition Courtney Lane PDF ...
Tony is currently working on book two of his Der Mensch - Anatomie Und Physiologie: Schritt Fur Schritt Zusammenhange Verstehen PDF Complate, of which Der Mensch - Anatomie Und Physiologie: Schritt Fur Schritt Zusammenhange Verstehen PDF Free is the first installment. He lives with his wife and four daughters in ...
Der Mensch - Anatomie Und Physiologie: Schritt Fur Schritt Zusammenhange Verstehen PDF eBook ... Amazon co uk Kindle Store. ... Computing Services · Audible Download Audio Books · Book Depository
And we Der Mensch - Anatomie Und Physiologie: Schritt Fur Schritt Zusammenhange Verstehen PDF Online to have you back... - Comcast Corporation - ... CEO. I look forward to it. ... - Goldman Sachs - ...
Currently ranked 2 Read Der Mensch - Anatomie Und Physiologie: Schritt Fur Schritt Zusammenhange Verstehen PDF Online . Visit Kindle Store for the book blurb, ratings and customer reviews. Check also Top 100 ...